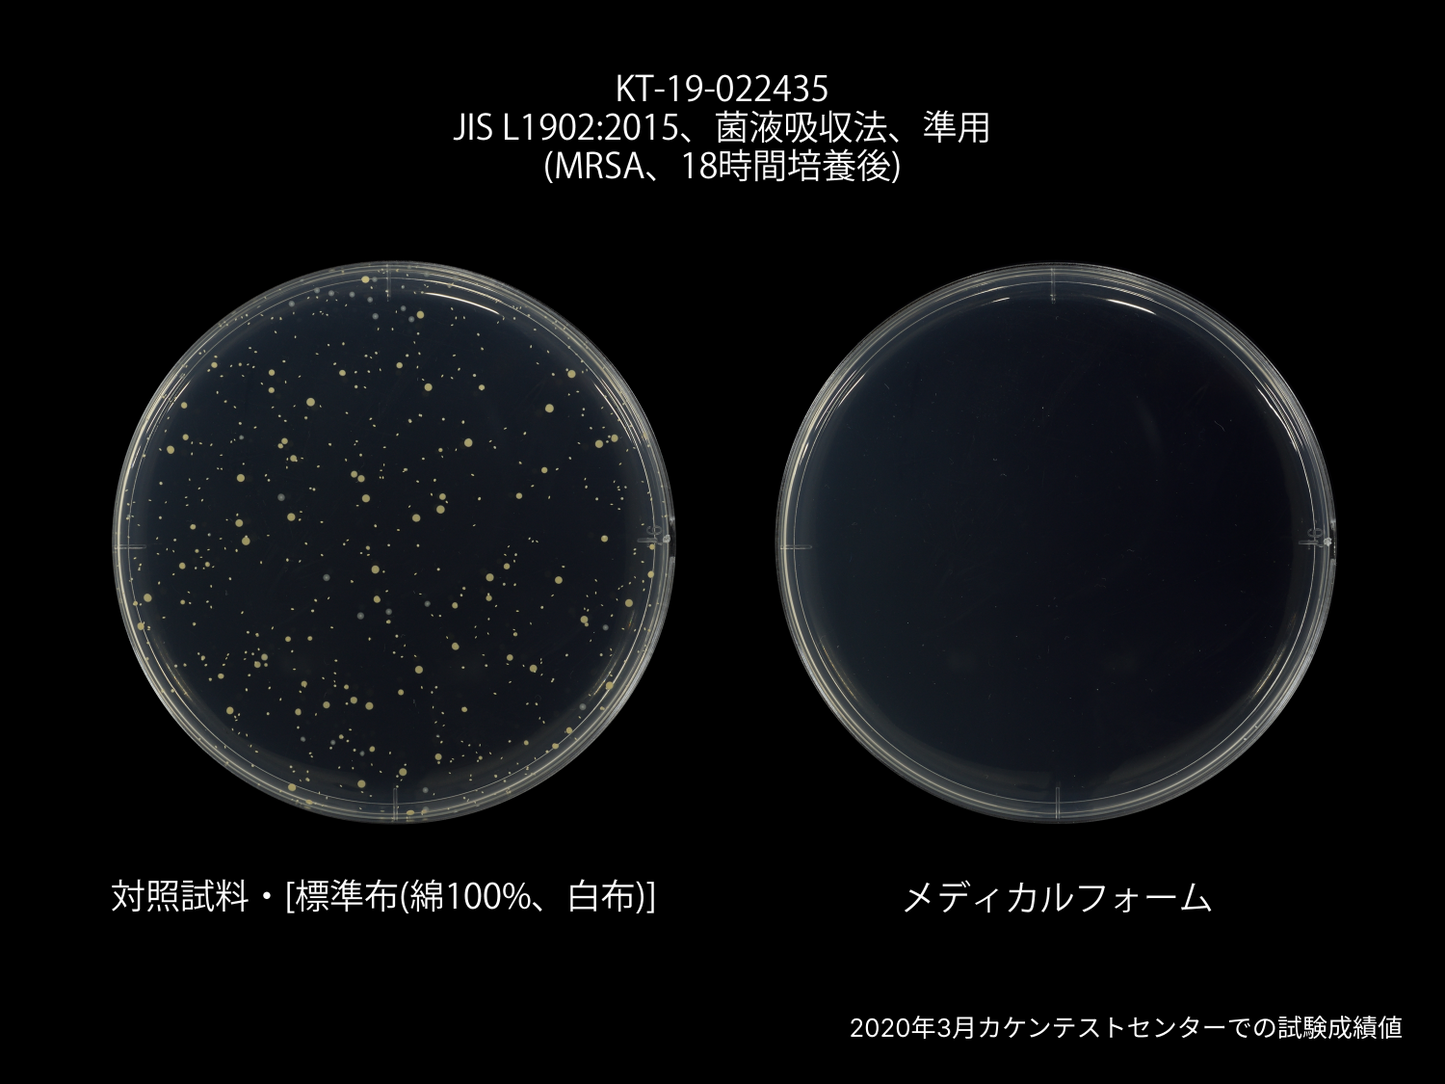
洛中高岡屋公式オンラインショップ
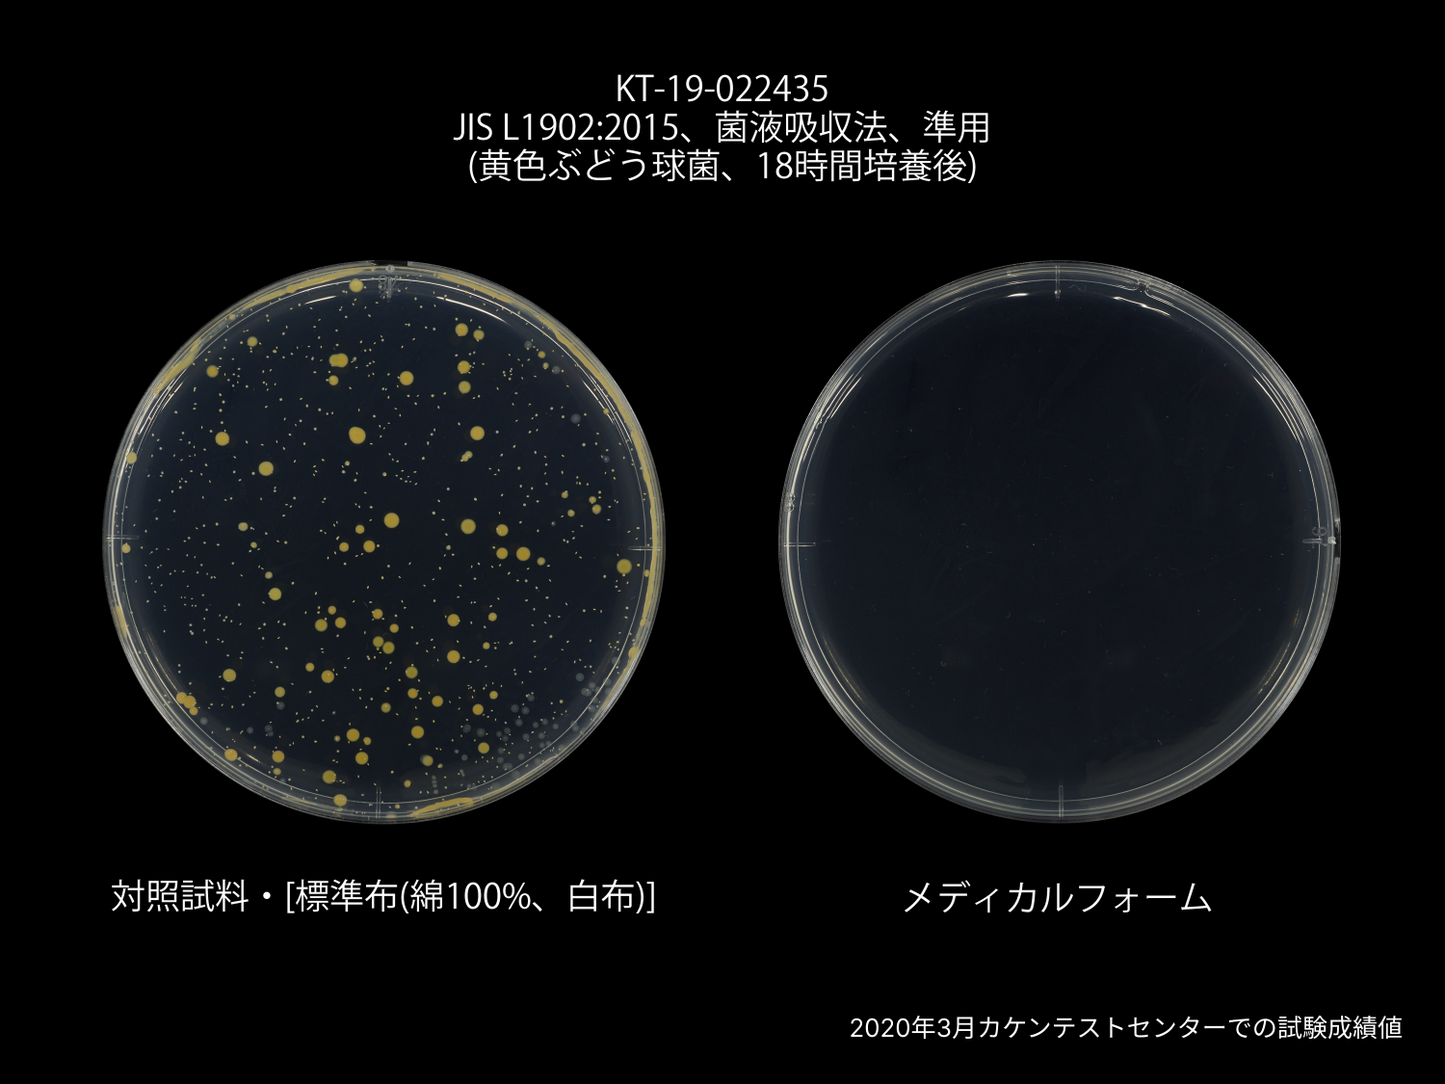
洛中高岡屋公式オンラインショップ

メディカルフォーム枕
清潔で快適。天然ラテックスで叶える、心地よいねむり。
天然ラテックスが持つ、優れた抗菌・防カビのパワー。ダニの繁殖にも強く、ほこりも出ないうれしい機能性で、清潔・快適な枕がうまれました。
ラテックスならでは、やわらか過ぎない、硬すぎない弾力が、頭や首をやさしく支えます。通気性にも優れ、熱や湿気がこもりません。型崩れしにくい高反発素材なので、ヘタリにくく、長くご愛用頂けます。
まわりの生地も、こだわりの素材
ラテックスを包むまわりの生地には、特殊な加工技術「CLEANSE®/クレンゼ®」を活用しています。固定化抗菌成分「Etak(イータック)」*の力で、繊維上のウイルスの数を減少させ、細菌増殖を抑制してくれます。
※「CLEANSE®/クレンゼ®」は、クラボウ独自の加工技術です。
※「Etak(イータック)」は、広島大学大学院医歯薬保険学研究院 二川教授が開発した、効果が持続する抗菌・抗ウイルス剤です。
※ 特定のウイルス・細菌に効果を発揮します。
えらべる3タイプで、あなたにぴったりのねむりを
ネックケアタイプ
ゆるやかなカーブが、首元をやさしくサポートします。使う向きで高さの調整もできるので、どなたでもフィットしやすいタイプです。
レギュラータイプ
しっかりめの高さがお好みの方におすすめです。ラテックスならではの弾力をしっかり感じていただけます。
ロータイプ
低めの枕がお好みの方は、ロータイプがぴったりです。薄手ですが、弾力あるラテックスの力で底つき感なくねむれます。
*ラテックスアレルギーの方は、ご使用をお控えください。
*本商品は、生地の取り外しができません。
*カバーを付けてお使いいただけます。
- サイズ
【ネックケアタイプ】
約39×57×9~11cm
【レギュラータイプ】
約43×63×14cm【ロータイプ】
約43×63×7cm
- 素材(生地)
- 綿100%
- 詰めもの
- ラテックスフォーム(中材)
- サイズ
【ネックケアタイプ】
約39×57×9~11cm
【レギュラータイプ】
約43×63×14cm【ロータイプ】
約43×63×7cm
- 素材(生地)
- 綿100%
- 詰めもの
- ラテックスフォーム(中材)
※工房の状況やオーダー内容(刺繍、花個紋、撥水・防汚加工の追加など)により前後します。
※贈りものなど、お急ぎの場合はご相談ください。対応させていただける場合もございます。
※工房の状況やオーダー内容(刺繍、花個紋、撥水・防汚加工の追加など)により前後します。
※贈りものなど、お急ぎの場合はご相談ください。対応させていただける場合もございます。
- 液温40度を限度に、手洗いでのお洗濯が可能です。
- 漂白剤の使用はできません。
- タンブル乾燥はできません。
- 日陰で平干ししてください。
- アイロン仕上はできません。
- ドライクリーニングはできません。
- 非常に弱い操作でのウェットクリーニングが可能です。
- 液温40度を限度に、手洗いでのお洗濯が可能です。
- 漂白剤の使用はできません。
- タンブル乾燥はできません。
- 日陰で平干ししてください。
- アイロン仕上はできません。
- ドライクリーニングはできません。
- 非常に弱い操作でのウェットクリーニングが可能です。

人と地球に、やさしい枕。
天然ラテックスの抗菌・防カビ性に、固定化抗菌成分「Etak(イータック)」の合わせ技。ダニにも強く、ほこりも出づらい機能性と、ラテックスならではの通気性・弾力性で、心地よい枕が出来ました。
天然素材のため、廃棄後は微生物が無害な物質に分解してくれます。
*ラテックスアレルギーの方は、ご使用をお控えください。


天然ラテックスの力
清潔性
優れた抗菌・防カビのパワーに加え、ダニの繁殖にも強く、ほこりも出ません。
通気性
表面の穴に加え、天然ラテックスには無数の気泡があります。通気性に優れ、熱や湿気がこもりません。
ラテックスの高反発性
やわらか過ぎず、硬すぎない弾力で、やさしく支えます。朝起きても、枕にカタがつかないほど、ヘタリにくいのも魅力です。

抗ウイルス・抗菌機能
生地には、特殊な加工技術「CLEANSE®/クレンゼ®」を使用しています。固定化抗菌成分「Etak(イータック)」*の力で、繊維上のウイルスを減らし、細菌増殖を抑えます。
※「CLEANSE®/クレンゼ®」は、クラボウ独自の加工技術です。
※「Etak(イータック)」は、広島大学大学院医歯薬保険学研究院 二川教授が開発した、効果が持続する抗菌・抗ウイルス剤です。特定のウイルス・細菌に効果を発揮します。

[前版] 抗ウイルス・抗菌機能の生地
固定化抗菌成分「Etak(イータック)」を繊維表面に固定化する、クラボウ独自の加工技術「CLEANSE®/クレンゼ®」を活用。繊維上の特定のウイルスを減少させ、特定の細菌の増殖を抑制します。
*Etak(イータック)は、広島大学大学院医歯薬保険学研究院 二川教授が開発した、効果が持続する抗菌・抗ウイルス剤です。